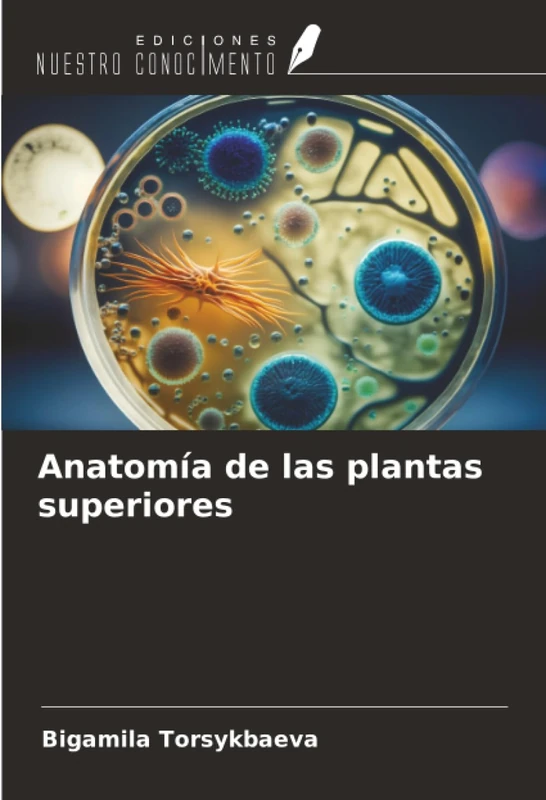
Anatomía de las plantas superiores

We can't find the internet
Attempting to reconnect
Something went wrong!
Hang in there while we get back on track

£62.00
Plantas leñosas: Botánica
Price data last checked 70 day(s) ago - refreshing...
We'll watch every seller, every day. One email when your price arrives.
It has never been this cheap. We have no record of a lower price.
£62 today · cheaper than every other day in the last 3 months
NEW HERE?
Amazon shows you one price. We show you all of them.
Tosheroon watches Amazon prices so you don't have to. Every product on Amazon has a price history — we make it visible. Set the price you'd actually pay, and we'll email you the second it gets there. No app, no account, one email.
WHAT'S ON THIS PAGE
when this has been cheap or pricey
where the price is heading next
all-time high & low, recent range
name your number, we'll email you
Price History & Forecast
Grey patches = out of stock. Cheaper = lower on the chart. Hover for exact prices.
Last 21 days • 21 data points (No recent data available)
Price Distribution
Price distribution over 21 days • 1 price levels
Price Analysis
Most common price: £62 (21 days, 100.0%)
Price range: £62 - £62
Price levels: 1 different prices over 21 days
Product Specifications
- Format
- paperback
- ASIN
- 6204915657
- Domain
- Amazon UK
- Release Date
- 30 June 2022
- Listed Since
- 01 July 2022
Barcode
No barcode data available
Similar Products You Might Like
Anatomía de las plantas superiores

ENFERMEDADES PERIIMPLANTARIAS

BIOMATERIALES EN ORTODONCIA

Interacción de las plantas con su entorno y plagas

HERRAMIENTAS BIOESTÁDICAS

Universalidad y particularidad de las sustancias aristotélicas

Gestión de enfermedades vegetales

Plantes ligneuses: Botanique

Fico-nanoecotoxicidad

Procedimientos estéticos conservadores

Plantas medicinales antidiabéticas

MANUAL DE LABORATÓRIO DE BIOQUÍMICA DE PLANTAS

Fiabilidad y mantenimiento

Reología de los materiales plásticos

CLASIFICACIÓN DE LOS INVERTEBRADOS: SABER DE ANIMALES

ESTÉTICA EN ORTODONCIA

Ecología y vida salvaje

Ecología, Biodiversidad y Sistemática

Derivados de materias primas

Reología de los extractos de frutas y verduras

Physiologie végétale

Gestión de las formaciones vegetales en las reservas naturales de Bontioli

DENDROMETRÍA: Medir los árboles y su crecimiento
